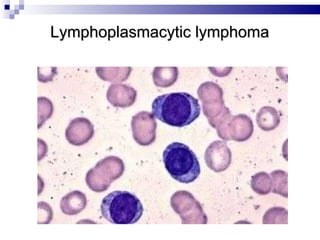
Lymphoplasmacytic lymphoma
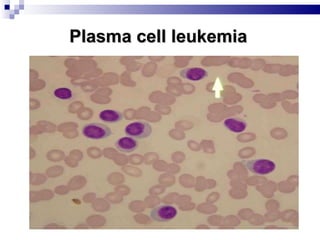
Plasma cell leukemia
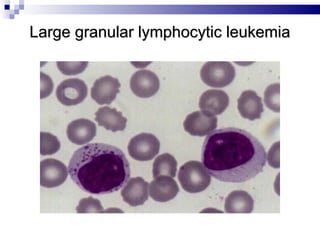
Large granular lymphocytic leukemia

The document discusses chronic lymphocytic leukemia (CLL) covering its diagnosis, treatment guidelines, and clinical presentations. Key points include the importance of accurate diagnosis through blood tests and morphology assessment, risk stratification for treatment decisions, and the evolving strategies for treatment that prioritize patient quality of life and long-term survival. The document also highlights recent advancements in therapy, including both chemotherapy and novel agents, emphasizing personalized treatment approaches based on patient comorbidities and prognosis.